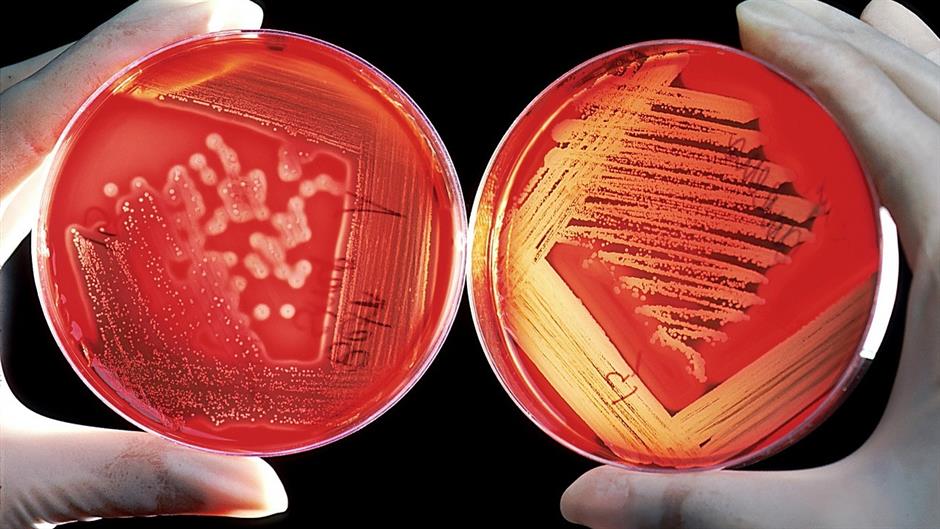

Ljudi s visokim nivoom željeza u krvi ne samo da su zaštićeni od anemije nego imaju i manji rizik od visokog kolesterola, pokazala je globalna studija.
Oglas
Naučnici s Imperial Collegea u Londonu, također, su otkrili da previše željeza u tijelu može povećati rizik od bakterijskih infekcija kože poput celulitisa i apscesa kože, piše Dnevni avaz.
Studija objavljena u časopisu PLOS Medicine proučavala je ulogu željeza u 900 bolesti te učinak njegovog niskog i visokog nivoa, a korišteni su podaci gotovo 500.000 ljudi.
Nedostatak željeza dovodi do ozbiljnih zdravstvenih problema. Oko 25 do 65 posto razlika u nivou željeza između pojedinaca uzrokuju genetski faktori, rekao je Beben Benyamin s londonskog Imperial Collegea.
N1 pratite putem aplikacija za Android | iPhone/iPad | Windows| i društvenih mrežaTwitter|Facebook | Instagram.
Kakvo je tvoje mišljenje o ovome?
Pridruži se raspravi ili pročitaj komentare
Oglas
Kakvo je tvoje mišljenje o ovome?
Pridruži se raspravi ili pročitaj komentare
Oglas
NAJČITANIJE
Oglas
Oglas
Najnovije
Oglas
Oglas